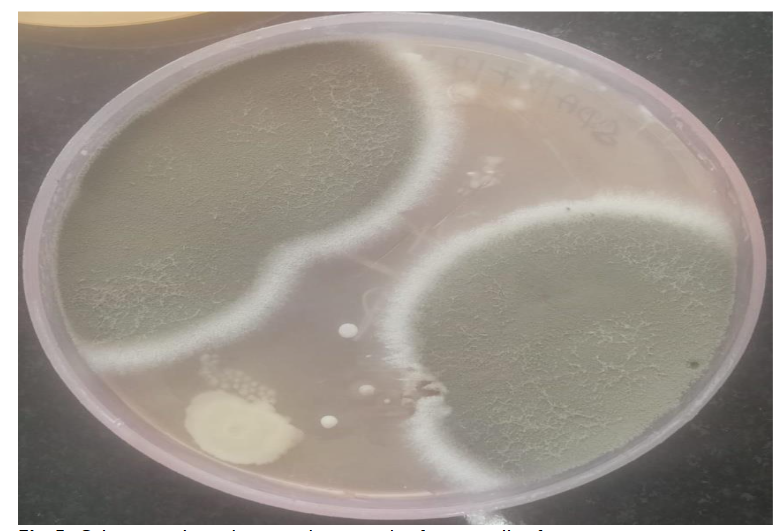
Fig 5: Culture medium showing the growth of aspergillus fumigatus.

Cutaneous Aspergillosis in Immunocompetent Patients
A Needle in the Skin: Unveiling Cutaneous Aspergillosis in an Immunocompetent Host: A Rare Case Report
DR. Leelavathy Ganesan, M.D, (Pathology) 1, DR. Shobana B, M.D, (Pathology) 2, DR. Kavitha M, M.D, (Pathology) 1, DR. Kasthuri Thilagam K, M.D, (Pathology) 3
- Assistant Professor, Department of Pathology,Government Medical College and ESI Hospital, Coimbatore.
- Associate Professor, Department of Pathology, Sree Balaji Medical College and Hospital, 7, CLC Works Road, Shankar Nagar, Chromepet, Chennai, Tamil Nadu – 600044
- Professor, Department of Pathology,Government Medical College and ESI HOSPITAL, Coimbatore.
OPEN ACCESS
PUBLISHED: 31 March 2025
CITATION: Ganesan L., Shobana., et al., 2025. A Needle in the Skin: Unveiling Cutaneous Aspergillosis in an Immunocompetent Host: A Rare Case Report. Medical Research Archives, [online] 13(3). https://doi.org/10.18103/mra.v13i3.6403
COPYRIGHT: © 2025 European Society of Medicine. This is an open-access article distributed under the terms of the Creative Commons Attribution License, which permits unrestricted use, distribution, and reproduction in any medium, provided the original author and source are credited.
DOI https://doi.org/10.18103/mra.v13i3.6403
ISSN 2375-1924
ABSTRACT
Primary Cutaneous aspergillosis is a rare but increasingly recognized infection, primarily affecting immunocompromised individuals. However, it can also occur in otherwise healthy individuals following trauma or environmental exposure to Aspergillus spores. We present here a case of cutaneous aspergillosis initially diagnosed through Fine Needle Aspiration cytology in an immunocompetent patient. This case highlights the utility of cytological examination in rapidly diagnosing this often-overlooked rare fungal infection especially in atypical or obscure clinical presentations, and emphasizes the importance of early detection and appropriate antifungal therapy for successful management.
Keywords:
Cutaneous Aspergillosis, Immunocompetent, Fine Needle Aspiration.
CASE REPORT
A Needle in the Skin: Unveiling Cutaneous Aspergillosis in an Immunocompetent Host: A Rare Case Report
Introduction
Aspergillus species are ubiquitous environmental molds that can cause a wide spectrum of diseases, from benign colonization to life-threatening invasive infections. The majority of Aspergillus infections affect the respiratory system, particularly in immunocompromised patients, but cutaneous aspergillosis, though less common, can also occur in immunocompetent individuals. It is further subdivided into primary and secondary cutaneous aspergillosis. Through direct inoculation, Primary cutaneous aspergillosis (PCA) develops in surgical wounds, burns, sites of maceration or repetitive skin trauma and catheter inlets. Secondary cutaneous aspergillosis (SCA) can spread hematogenously or directly from nearby sites like the lungs or paranasal sinus. Though, SCA is more prevalent than PCA, PCA has the potential to spread and result in systemic infection, which can raise treatment expenses and lengthen hospital stays. It can also induce morbidity that results in limb loss and death. While the condition is often seen in patients with immunosuppression, it can also affect immunocompetent individuals, especially those exposed to soil, decaying organic matter or other environmental sources of Aspergillus spores.
It is often challenging to diagnose this condition due to its nonspecific clinical presentation and can easily be mistaken for other dermatologic conditions including cutaneous neoplasms. Tissue biopsy and culture had been the two time-consuming traditional diagnostic techniques for fungal infections. On the other hand, fine needle aspiration (FNA) cytology provides a quick and less invasive diagnostic alternative that may expedite the identification of the causative pathogen. Here, we describe a case of cutaneous aspergillosis initially diagnosed by FNA cytology in an immunocompetent patient and later confirmed by histopathology and fungal culture, with a focus on the clinical, diagnostic and therapeutic aspects of this rare condition.
This case report highlights the importance of considering Cutaneous Aspergillosis in the differential diagnosis of chronic skin lesions, especially in individuals with exposure to environmental sources of Fungal spores. It also demonstrates the role of FNA cytology in facilitating a rapid and accurate diagnosis. Early diagnosis aids the clinician in proper and timely management and follow-up to reduce the high morbidity associated with this condition.
Case Report:
A 64 year old female presented to the Dermatology OPD with history of swelling in the dorsum of right hand for the past 3 months. She is a farmer by occupation and was involved in wood cutting. She had previous history of similar lesion in the index finger for which incision and drainage was done. For that, no record was available. She reported no previous history of trauma to the area, but noted that she had been working with soil and compost shortly before the lesion appeared.
On clinical examination, the patient had a soft to firm swelling in the dorsum of right hand of size 3 x 3 cm. Clinical diagnosis was ganglion cyst or lipoma. There was no associated lymphadenopathy or systemic signs of infection such as fever. Routine laboratory tests, including complete blood count (CBC), liver and renal function tests, and chest X-ray, were all unremarkable. FNA Cytology of the lesion was performed using a 22-gauge needle and about 1.5 ml of pus was aspirated. Air dried and alcohol fixed smears were made and the material was sent to microbiology for culture and sensitivity and also for fungal culture. FNAC smears were moderately cellular and showed epithelioid granulomas and plenty of scattered, degenerated neutrophils and histiocytes with few characteristic acute angle branching and septate fungal hyphae and fungal spores as well, suggestive of an Aspergillus species.


PAS Stain in cytology smears also confirmed the same. Excision biopsy was done and histopathology sections showed an unremarkable epidermis with deep dermis showing organised collections of neutrophils with necrotic centre and multiple septate fungal hyphae with acute angle branching. Spores were also noted. PAS and GMS staining was done and confirmed the presence of fungal elements.

Upon diagnosis of cutaneous aspergillosis, the patient was started on oral voriconazole, the antifungal agent of choice for Aspergillus infections. Local wound care, including debridement of necrotic tissue and maintenance of a moist free environment to promote healing, was also initiated.
Over the next four weeks, the lesion showed significant improvement, with reduced size and no recurrence. The patient continued oral voriconazole for a total duration of three months. No systemic complications were observed, and the patient remained afebrile throughout the course of treatment. Voriconazole was gradually tapered, and the patient was discharged with instructions for routine dermatologic follow-up. Follow-up visits revealed complete resolution, confirming successful treatment.
Discussion
Primary Cutaneous aspergillosis remains a relatively rare entity, often seen in immunocompromised individuals such as those with leukemia, organ transplant recipients or HIV/AIDS patients. However, this case demonstrates that even immunocompetent individuals can develop cutaneous aspergillosis, particularly after trauma or environmental exposure to Aspergillus spores. Upon reviewing the earlier published articles, only nine instances of post-traumatic or post-operative PCA were reported in immunocompetent people. Occupational exposure, as seen in this patient, is a recognized risk factor for fungal inoculation, particularly in individuals working with soil, compost or decaying plant matter. According to Patterson et al., 5% of instances of invasive aspergillosis involved the skin too. Clinically, cutaneous aspergillosis can present as a chronic, painful ulcer or abscess, which may resemble bacterial infections or other chronic skin conditions such as pyoderma gangrenosum, skin malignancies, or granulomatous diseases. As such, it is important to include fungal infections in the differential diagnosis of non-healing skin lesions, particularly when there is a history of trauma or environmental exposure.
The common saprophytes of the Aspergillus genus that live in soil and water are the cause of cutaneous aspergillosis. A. fumigatus, the most prevalent pathogen is linked to disseminated illness, while A. flavus or A. terreus often cause the less common primary skin infections. Fungal cultures were once used to diagnose cutaneous aspergillosis, which could take several days for results and during the early stages of infection, cultures might not be positive. A biopsy with the presence of the fungus is required for a definitive diagnosis of Cutaneous fungal infections. Although fungal culture is necessary for species identification and complements morphology, not all fungi thrive on culture medium, and samples submitted for culture may not be representative most of the times. Therefore, in the majority of situations, morphology continues to be the primary diagnostic method.
Numerous earlier publications address how the diagnosis is determined by the clinical characteristics as well as the findings of the fungal culture, skin biopsy, serology and imaging studies. In contrast, FNA provides a rapid, less invasive diagnostic alternative, yielding quick results that can guide prompt antifungal therapy. The role of FNA in diagnosing fungal infections is an underutilized approach in dermatologic practice, yet it offers substantial benefits in terms of accurate diagnosis and prompt patient treatment. When present, cutaneous swellings are readily accessible to FNAC. When collected, sufficient and representative cytological material can consistently provide a diagnosis. On the basis of morphology, Aspergillus and Mucor are easily distinguished from one another. Mucor is distinguished by wide, non-septate hyphae that branch at a right angle. In this case, patient is old-aged, immunocompetent and identified with fungal elements on FNAC. In instances of Cutaneous Aspergillus, species identification is crucial. The most prevalent kind found in India is A. flavus. Species identification has epidemiological relevance since it varies on different geographic regions, which helps with diagnosis in challenging situations, but it is not very significant to patient care.
Narrow septate hyphae with acute-angle branching is seen in tissue sections of our case, particularly when special stains are used (PAS and GMS). In our case, cytological examination is pivotal in identifying Aspergillus species, followed by biopsy with fungal stains confirmed the diagnosis. Treatment of cutaneous aspergillosis typically involves systemic antifungal therapy with agents like voriconazole, itraconazole, or amphotericin B, depending on the severity of the infection and the presence of underlying conditions. The fungal etiology is supported by the response to agents like Voriconazole as in our instance. There have been very few documented occurrences of cutaneous aspergillosis in immunocompetent people so far. The medication’s effectiveness in treating aspergillosis is demonstrated by the striking response to various antifungals including itraconazole. While some studies contend that voriconazole is utilized in cases of resistance, numerous studies maintain that it is still the best option due to its demonstrated effectiveness against Aspergillus species. In this case, the patient responded well to voriconazole therapy, with complete resolution of the lesion after three months of treatment.
Conclusion
Cutaneous aspergillosis, though rare, should be considered in the differential diagnosis of chronic or non-healing skin ulcers, particularly in individuals with direct exposure to Aspergillus spores. The diagnosis can be challenging, but fine needle aspiration cytology provides a rapid, minimally invasive technique that facilitates early identification and prompt initiation of appropriate treatment. This case highlights the value of cytological techniques in diagnosing cutaneous fungal infections and underscores the importance of recognizing cutaneous aspergillosis, even in immunocompetent individuals. Thus, aspiration cytology is essential for the prompt and conclusive identification of fungal infections in instances when the radiological and clinical signs of malignancy are suspected.
References:
- Sharma VK, Krishna SG, Gupta C, Kumawat M, et al. Cutaneous aspergilloma in an immunocompetent patient treated with Itraconazole. Indian J Dermatol Venereol Leprol. 2011;77:626. doi: 10.4103/0378-6323.84080.
- Bongomin F, Gago S, Oladele RO, Denning DW, et al. Global and Multi-National Prevalence of Fungal Diseases-Estimate Precision. J Fungi (Basel). 2017 Oct 18;3(4):57. doi: 10.3390/jof3040057.
- Nerune SM, Arora S, Kumar M, et al. Cytological Diagnosis of Primary Cutaneous Aspergillosis Masquerading as Lipoma in a Known Case of Lepromatous Leprosy. J Clin of Diagn Res. 2017;11(5):ED36-ED37. doi: 10.7860/JCDR/2017/27864.9933.
- Avkan-Oğuz V, Çelik M, Satoglu IS, Ergon MC, Açan AE, et al. Primary Cutaneous Aspergillosis in Immunocompetent Adults: Three Cases and a Review of the Literature. Cureus. 2020;12(1):e6600. doi: 10.7759/cureus.6600.
- Sharma D, Mahajan N, Rao S, Khurana N, Jain S, et al. Invasive maxillary aspergillosis masquerading as malignancy in two cases: Utility of cytology as a rapid diagnostic tool. J Cytol. 2012;29:194-96. doi: 10.4103/0970-9371.101171.
- Kalyani prava gouda, Pritilata panda, Indrani mohanty, Upasana das, et al. Evaluation of Fine Needle Aspiration Cytology versus Culture for Laboratory Diagnosis of Subcutaneous Mycosis. National Journal of Laboratory Medicine. 2022;12(2):PO31- PO34. doi.org/10.7860/NJLM/2023/57361.2720.
- Tatara AM, Mikos AG, Kontoyiannis DP, et al. Factors affecting patient outcome in primary cutaneous aspergillosis. Medicine. 2016;95(26):e3747. doi:10.1097/MD.0000000000003747.
- Patterson TF, Kirkpatrick WR, White M, Hiemenz JW, Wingard JR, Dupont B, Rinaldi MG, Stevens DA, Graybill JR, et al. Invasive aspergillosis. Disease spectrum, treatment practices, and outcomes. I3 Aspergillus Study Group. Medicine (Baltimore). 2000 Jul;79(4):250-60. doi: 10.1097/00005792-200007000-00006.
- Kumar Behera S, Patro M, Mishra D, Bal A, Behera B, Sahoo S. et al. Fine needle aspiration in aspergilloma of frontal sinus: a case report. Acta Cytol. 2008 Jul-Aug;52(4):500-4. doi: 10.1159/000325562.
- Mohapatra S, Xess I, Swetha JV, Tanveer N, Asati D, Ramam M, et al. Primary cutaneous aspergillosis due to Aspergillus niger in an immunocompetent patient. Indian J Med Microbiol.2009;27(4):367-370. doi: 10.4103/0255-0857.55462.
- Ajith C, Dogra S, Radotra BD, Chakrabarti A, et al. Primary cutaneous aspergillosis in an immunocompetant individual. J Eur Acad Dermatol Venerol. 2006 Jul;20(6):738-9. doi: 10.1111/j.1468-3083.2006.01465.x.
- D’Antonio D, Pagano L, Girmenia C, Parruti G, Mele L, Candoni A, Ricci P, Martino P, et al. Cutaneous aspergillosis in patients with haematological malignancies. Eur J Clin Microbiol Infect Dis. 2000 May;19(5):362-5. doi: 10.1007/s100960050495.